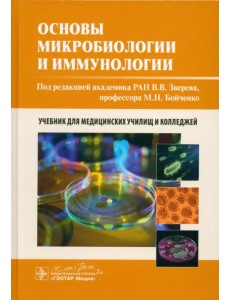
Основы микробиологии и иммунологии. Учебник Основы микробиологии и иммунологии. Учебник

ГЭСН 81-02-15-2001. Часть 15. Отделочные работы
-
20.13 €
-+
Государственные сметные нормативы. Государственные элементные сметные нормы на строительные и специальные строительные работы (далее - ГЭСН) предназначены для определения потребности в ресурсах (затрат труда рабочих-строителей, машинистов, времени эксплуатации строительных машин и механизмов, материальных ресурсов) при выполнении ремонтно-строительных работ и для составления на их основе сметных расчетов (смет) на производство указанных работ ресурсным и ресурсно-индексным методами. ГЭСН являются исходными нормами для разработки других сметных нормативов: единичных расценок федерального, территориального и отраслевого уровней, индивидуальных и укрупненных сметных нормативов.